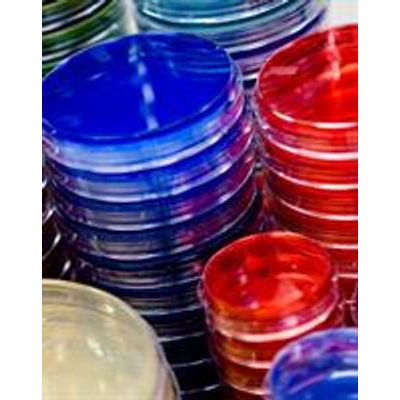

- Home
- Companies
- Dalynn Biologicals
- Products
Dalynn Biologicals products
Diagnostic Microbiology
Dalynn - Model BA20-500 - Bottled
Acetone. Size 500 mL.
Dalynn CHROMagar - Model 1-MMX-096 - Powders
Acinetobacter Agar Plate - 10 /package. Size Package.
Dalynn - Model DD10-25 - Microbiology Disks
Our 0129 Disks are used for the differentiation of vibrios from other gram-negative bacteria. Shewan and Hodgkiss recognized the sensitivity of vibrios to the vibrio-static agent 0129 (2,4-diamino-6.7-di-isopropyl-pteridine phosphate) in 1954. 0129 was found to be useful in the differentiation of vibrios from other gram-negative bacteria especially aeromonads. which are characteristically resistant to 0129. Among the genera, different species of vibrios show different sensitivities to 0129; this can be used as a diagnostic feature as antimicrobial disks of different concentrations can be used to determine their degree of sensitivity.
Diagnostic Microbiology
Dalynn - Model PA20 - Plated Media
Acanthamoeba Agar. Size 10/pkg.
Dalynn - Model RA45-250 - Reagents
Our Voges-Proskauer (VP) Reagents when used with MR-VP Broth can differentiate organisms based on their ability to produce the end product, acetylmethylcarbinol (acetoin). from glucose fermentation. This characteristic can be used to aid in the differentiation between genera
Dalynn - Model 8-EZS5 - Sterilization Indicators
EZ Test/B. stearothermophilus 10/5th. Size 100/box.
Dalynn - Model VA10-1 - Supplements and Enrichments
Acetylcysteine 100 mg / vial. Size 10/pkg.